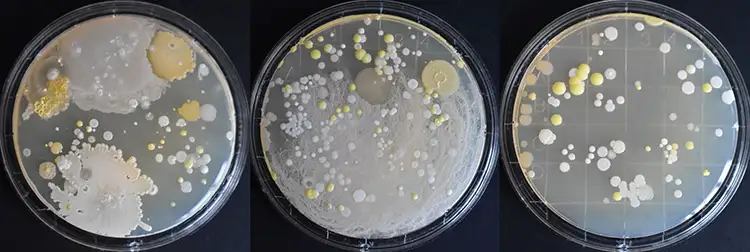

By Liz Stevens, writer, UV Solutions
As computers have become embedded in seemingly every electrical device, touchscreens too have begun to turn up everywhere. The interface is used to get cash from the ATM, to check in for a doctor’s appointment, to authorize payment at stores and to order a meal and play video games at fast food restaurants. In some public settings, hand sanitizer is provided next to the touchscreen device, allowing users to decrease their exposure to bacteria and infectious diseases. Researchers at the Ulm University of Applied Sciences in Ulm, Germany, have developed an innovative approach to touchscreen hygiene – using an optical phenomenon and automated UV-C LEDs to rapidly zap contamination on touchscreens.
Through research and development led by Professor Dr. Martin Hessling, with Ph.D. student Ben Sicks and master’s student Kilian Noller, the Ulm University team has developed a side-mounted UV-C LED system with a quartz overlay pane that rapidly disinfects touchscreens. This automated solution, the basis for Hessling’s start-up, offers user-safe disinfection, eliminating the need for manual cleaning and the use of cleaning solutions with harmful residues. Lab testing of the technology as integrated with a medical device has shown up to 99.9% bacterial reduction (including MRSA surrogates) on touchscreens with a one-second UV-C exposure, indicating that this technology is suitable for high-traffic environments. Sicks, Noller and Hessling’s innovation follows on the heels of the work described by Sicks, Oksana Gurow and Hessling in “Future Disinfection of Touchscreens by Far UV-C LEDs: A Feasibility Study,” in the 2024 Quarter 3 issue of UV Solutions. 1
Hessling and his team developed a self-disinfecting touchscreen system and implemented it in an existing medical device – a Cryo7 cryotherapy device from Zimmer MedizinSysteme GmbH. This disinfection system uses 36 UV-C-emitting LEDs with a wavelength of 275 nm, driven by a microcontroller circuit that communicates with the Cryo7 to integrate the disinfection process. While the researchers had earlier studied the use of UV-A and Far UV-C LEDs, in their most recent work they have used UV-C LEDs due to their affordability, durability and disinfecting efficiency.
Disinfection is achieved by irradiating UV-C laterally into a 4 mm-thick quartz glass pane that the team added over the front of the existing touchscreen, with arrays of UV-C LEDs placed around the edge of the pane. The UV-C energy is focused laterally into the glass to generate total internal reflection (TIR). “We work with various UV touchscreen disinfection systems,” Hessling explained, “all of which are similar and based on total internal reflection, i.e., the UV is coupled into a quartz plate from the side and then (almost) does not come out again. This means that a user in front of the touchscreen is practically not exposed to radiation, but microorganisms on the front screen are exposed.”
Hessling described the TIR optical phenomenon at work. “This can be described in two ways,” he said. “In geometric optics, at the point where a microorganism is on the screen, total internal reflection does not occur because the necessary difference in refractive index is not existent and the ‘UV-C beam’ passes through the microorganism from the quartz plate.” Any contamination of the front glass surface therefore affects the total internal reflection, disrupting the internal reflection and allowing the escape of targeted disinfecting UV-C irradiation only at the contaminated point on the glass surface. Hessling then described the wave optics approach. “From a wave optics perspective,” he said, “the electromagnetic field (evanescent field) protrudes slightly (< 1 µm) beyond the quartz plate even in the case of total reflection, and it therefore also irradiates the surface. The evanescent field is a consequence of the wave property of radiation. During the transition between two media, such as total internal reflection in an optical waveguide, the electromagnetic field extends slightly beyond the waveguide and thus irradiates areas that, according to geometric optics, should be radiation-free.”
To protect users from exposure, the system includes a two-stage safety shutdown feature. To sense a user’s imminent contact with the touchscreen, the system includes an infrared proximity sensor to augment the touchscreen’s capacitive sensing. The infrared sensor recognizes a user’s movement toward the touchscreen and responds by shutting down the process. The cryotherapy device’s own touch sensors serve as a second-stage shutdown; if a user touches the screen during disinfection irradiation, the system is programmed to halt. To further protect users, the disinfection activity can be timed. “We don´t intend to disinfect continuously,” Hessling said, “but only for a few seconds after a change of the user. However, the system can be set to disinfect continuously and some of our risk assessments were performed under the assumption that a user is in front of the touchscreen for a longer period.”

LED numbers
The contaminant used in the study is non-pathogenic Staphylococcus carnosus as a surrogate for pathogenic Staphylococcus aureus. A rapid disinfection of staphylococci was achieved without compromising usability and user safety. The prototype device demonstrated a bacterial reduction of 99.96% or 3.4 log levels in less than one second.
Hessling’s team currently is working on improving the device and generalizing it for use with other touchscreen equipment. “We are also working to reduce the number of LEDs required and to increase the LED lifetime, which is especially interesting for Far UV-C LEDs,” said Hessling. “In addition, we are addressing the quartz pane, which can be brittle, making it a less-than-ideal surface that allows a small amount of irradiation to escape.”
At this stage in the start up, Hessling invites input from companies that build touchscreens for medical or public applications or that install them in systems. “We have had little feedback in this area,” he said. “We believe this is because not many people are aware of this approach yet. We had an instance where a hygiene expert asked us to develop something for touchscreen disinfection. When we explained that we already had it, they didn’t believe us!”
Professor Hessling’s innovation has commercial potential for infection control on everyday touch interfaces, enhancing hygiene and safety in healthcare settings and public environments worldwide. Hessling is the honoree for the 2025 UVLaunch award, recognized for an innovative UV start up or start up idea.
For more information, email Hessling at martin.hessling@thu.de.
References
- Sicks, B., Gurow, O., & Hessling, M. (2024). Future disinfection of touchscreens by Far UV-C LEDs: A feasibility study. UV Solutions, Quarter 3. https://uvsolutionsmag.com/articles/2024/future-disinfection-of-touchscreens-by-far-uv-c-leds-a-feasibility-study/
